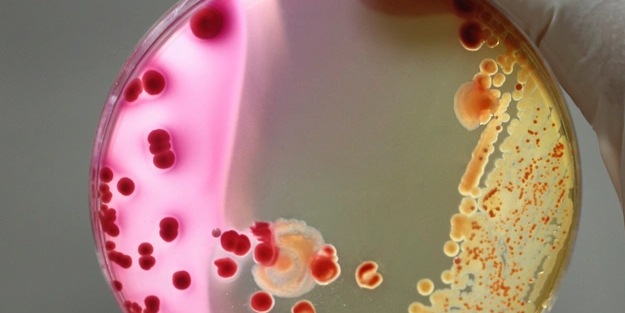
NASA bakteri keşfetti: Dünya'da benzeri görülmemiş türlere dönüştüğü ortaya çıktı

Ukrayna'nın yeni Dışişleri Bakanlığı Sözcüsü: Yapay zeka! Diplomasi alanında bir ilk
Milli İradenin Sesi Yeni Akit
Türkiye ve dünyadaki gelişmeleri yakından takip etmek için Google listenize Yeni Akit'i ekleyin.

Ukrayna Dışişleri Bakanlığı, açıklamalarının okunması için dijital bir sözcünün kullanılmasının 'tarihte bir ilk olacağını' ifade etti.
usya ile savaşın Şubat 2022'den bu yana sürdüğü Ukrayna'nın Dışişleri Bakanlığı, yeni sözcüsünü 1 Mayıs Çarşamba günü kamuoyuna sundu. Buna göre, yapay zeka tarafından oluşturulan Victoria Shi, bakanlık adına resmi açıklamaları okuyacak.
The Guardian gazetesinin aktardığına göre, Victoria Shi, Ukraynalı şarkıcı Rosalie Nombre üzerine modellendi. Bakanlıktan yapılan açıklamada, 'açıklamaların okunması için dijital bir sözcünün kullanılmasının tarihte bir ilk olacağı' belirtildi. Açıklamalar insanlar tarafından yazılmaya devam edecek; açıklamaları ise Victoria Shi okuyacak.
'AÇIKLAMALARI GERÇEK İNSANLAR YAZACAK'
Siyah bir kıyafet giyen yeni sözcü, sosyal medyada yayınlanan video mesajda, kendisini 'dijital bir insan' olan Victoria Shi olarak tanıttı. Shi, bakanlığın açıklamalarını okurken elleri ve başıyla insana benzer bir şekilde jest ve mimiklerde bulunabiliyor. Bakanlığın basın servisi, Shi'nin yapacağı açıklamaların yapay zeka ile oluşturulmayacağının, bunun yerine 'gerçek insanlar tarafından yazılıp teyit edileceğinin' altını çizdi.
Dışişleri Bakanı Dmytro Kuleba da konuya ilişkin açıklamasında, "Yapay zeka bize sadece görsel kısmı oluşturma kısmında yardım etti" dedi. Kuleba, yeni sözcünün 'dünyadaki hiçbir diplomatik servisin henüz yapmadığı teknolojik bir sıçrama olduğunu' da söyledi. Kuleba'ya göre, böyle bir adım atılmasının sebebi, zaman ve kaynaktan tasarruf etmekti. Shi'nin Rusya-Ukrayna savaşı ile ilgili sanal gerçeklik içerikleri de üreten 'Game Changers' (Oyunu Değiştirenler) ekibi tarafından yaratıldığı belirtildi. Yeni sözcü ise ismini 'zafer' (İngilizcede victory) ve Ukraynaca yapay zeka kelimelerinden (shtuchniy intelekt) aldı.
'ONLAR İKİ FARKLI İNSAN'
Shi, şu anda Rusya'nın kontrolü altında bulunan Ukrayna'nın doğusundaki Donetsk bölgesinde doğan şarkıcı Rosalie Nombre üzerine modellendi. Bakanlık, Nombre'nin bu sürece herhangi bir ödeme almadan katıldığı bilgisini verdi. Bakanlık, Shi ve Nombre'nin 'iki farklı insan' olduğunu ve açıklamaları Shi'nin yapacağını vurguladı. Bu yöntemle yapılacak açıklamalarda, herhangi sahte bir açıklamanın önüne geçebilmek için bir QR kodu da bulunacak; bu kod, bakanlığın sitesindeki yazılı açıklamaya bağlanacak.